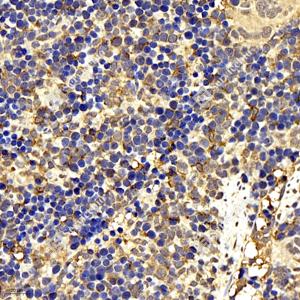

Anti-Heme Oxygenase 1 Rabbit pAb
- 100 μL
产品信息
蛋白质全称 | 血红素加氧酶1 |
别名 | HMOX1, HMOX1D, HO-1, HSP32, bK286B10, heme oxygenase 1 |
Uniprot ID | P14901 |
免疫原 | KLH偶联的小鼠Heme oxygenase 1合成肽 |
抗体亚型 | IgG |
纯化方式 | 亲和纯化 |
亚细胞定位 | 内质网膜 |
应用
| 应用 | 物种 | 稀释 | 阳性样品 |
| IHC/IF 免疫组织化学/免疫荧光 | 小鼠 | 1: 200-1: 2000 | 肺, 脾 |
背景
Heme oxygenase cleaves the heme ring at the alpha methene bridge to form biliverdin. Biliverdin is subsequently converted to bilirubin by biliverdin reductase. Under physiological conditions, the activity of heme oxygenase is highest in the spleen, where senescent erythrocytes are sequestrated and destroyed. Exhibits cytoprotective effects since excess of free heme sensitizes cells to undergo apoptosis.
图像
| IHC检测Heme Oxygenase 1蛋白(货号 GB11104). 样品: 小鼠肺, 4%多聚甲醛 (货号G1101) 固定12-24小时. 抗原修复: 柠檬酸抗原修复液(干粉, pH 6.0) (G1201), 98℃, 20分钟. —抗: 1: 200稀释, 4℃ 孵育过夜. 二抗: HRP标记山羊抗兔IgG (H+L) (货号GB23303), 1: 200稀释, 室温孵育1小时. |
| IHC检测Heme Oxygenase 1蛋白(货号 GB11104). 样品: 小鼠脾, 4%多聚甲醛 (货号G1101) 固定12-24小时. 抗原修复: 柠檬酸抗原修复液(干粉, pH 6.0) (G1201), 98℃, 20分钟. —抗: 1: 200稀释, 4℃ 孵育过夜. 二抗: HRP标记山羊抗兔IgG (H+L) (货号GB23303), 1: 200稀释, 室温孵育1小时. |
| IHC检测Heme Oxygenase 1蛋白(货号 GB11104). 样品: 大鼠肺, 4%多聚甲醛 (货号G1101) 固定12-24小时. 抗原修复: 柠檬酸抗原修复液(干粉, pH 6.0) (G1201), 98℃, 20分钟. —抗: 1: 200稀释, 4℃ 孵育过夜. 二抗: HRP标记山羊抗兔IgG (H+L) (货号GB23303), 1: 200稀释, 室温孵育1小时. |
| IHC检测Heme Oxygenase 1蛋白(货号 GB11104). 样品: 大鼠脾, 4%多聚甲醛 (货号G1101) 固定12-24小时. 抗原修复: 柠檬酸抗原修复液(干粉, pH 6.0) (G1201), 98℃, 20分钟. —抗: 1: 200稀释, 4℃ 孵育过夜. 二抗: HRP标记山羊抗兔IgG (H+L) (货号GB23303), 1: 200稀释, 室温孵育1小时. |
| IF检测Heme Oxygenase 1蛋白(货号 GB11104)(红色). 样品: 小鼠脾, 4%多聚甲醛 (货号G1101) 固定12-24小时. 抗原修复: Tris-EDTA抗原修复液(pH 9.0) (G1203), 98℃, 20分钟. 封闭: 3% BSA(货号GC305010)的PBS溶液, 室温孵育30分钟. —抗: 1: 2000稀释, 4℃ 孵育过夜. 二抗: Cy3标记山羊抗兔IgG (H+L) (货号GB21303), 1: 300稀释, 室温孵育1小时. |
| IF检测Heme Oxygenase 1蛋白(货号 GB11104)(红色). 样品: 大鼠脾, 4%多聚甲醛 (货号G1101) 固定12-24小时. 抗原修复: Tris-EDTA抗原修复液(pH 9.0) (G1203), 98℃, 20分钟. 封闭: 3% BSA(货号GC305010)的PBS溶液, 室温孵育30分钟. —抗: 1: 2000稀释, 4℃ 孵育过夜. 二抗: Cy3标记山羊抗兔IgG (H+L) (货号GB21303), 1: 300稀释, 室温孵育1小时. |
储存
| 储存条件 | 在-20℃下储存一年, 避免反复冻融. |
| 储存缓冲液 | 含0.15% ProClin300防腐剂, 100 μg/mL牛血清白蛋白和50%甘油的磷酸盐缓冲液. |
注意:
1.本产品仅供研究使用.
2.建议用一抗稀释液(G2025)稀释本产品.
| 货号 | 名称 | 规格 | 价格 | 操作 |
|---|
| 货号 | 名称 | 规格 | 价格 | 操作 |
|---|